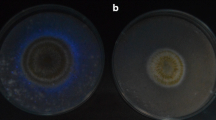

Abstract
Globally, of all mycotoxins, aflatoxins present a significant threat to human and animal health and has resulted in the introduction of strict food regulatory limits to protect public health. A systematic review, was performed to elucidate the rationale applied in establishing aflatoxin standards and evaluate the economic impacts of these. The focus was peanuts, a principal trading commodity susceptible to aflatoxin contamination. Results revealed that although regulations are established in many countries, there is huge disparity in the maximum limits applied due to different methodologies used when considering exposure assessment. Moreover, in countries most affected by aflatoxin contamination in peanuts, few, if any standards exist. In the case of risk assessments, knowledge gaps identified include the impact of climate change on peanut aflatoxin contamination, the role of aflatoxins in child stunting, Kwashiorkor and immunomodulation and a lack of occurrence and exposure data in many developing countries from contaminated peanuts. Few quantitative studies evaluating the impact of aflatoxin regulations on trade exist and evidence is lacking in terms of what happens to exports that do not meet regulatory requirements. Evidence does suggest a lack of knowledge of the extent of the aflatoxin problem, associated health risks and mitigation strategies in developing countries. A hugely important factor that needs to be highlighted is that while there is a fundamental right for sufficient, safe, nutritious food, in many cases in low-income and lower middle-income countries there exists an incredibly difficult and complex trade-off between food security and food safety.
Similar content being viewed by others
Introduction
Availability of safe food is a fundamental human right that is in place to sustain life, promote health and shield from food insecurity and malnutrition. Food safety refers to the conditions and practices that preserve the quality of food to prevent contamination and food-borne illnesses. It is an integrated ‘farm to fork’ approach that encompasses animal health, animal welfare, animal nutrition, plant health, food production, food processing, storage, transport, import and export, and retail sales. Hazards can arise from poor agricultural practices, lack of hygiene along the food supply chain, sub-standard control in food processing and deliberate or accidental contamination. Therefore, decisions made in the area of food safety must protect public health; protect food businesses and those that may underwrite their insurances while maintaining a focus on One Health. Unfortunately, contamination and adulteration of food is an ever-increasing global problem and there are major challenges that will have a direct impact.
One of the greatest threats to food safety and human health globally is the contamination of staple crops with mycotoxins. Mycotoxins are secondary metabolites of filamentous fungi, many of which have been implicated in human and animal disease (CAST 2003; Wu et al. 2013). Their production is driven by specific environmental conditions, in particular temperature and moisture (Magan et al. 2011), however, other factors including inoculum concentrations, microbial interactions, insect infestation, physical damage, availability of nutrients and carbon dioxide levels will promote infection and contamination (CAST 2003). The Food and Agriculture Organization (FAO) estimated global food crop contamination with mycotoxins to be 25%. Although the origin and the reasoning behind this statement dating back to 1985 is largely unknown, recent mycotoxin occurrence data at levels above the EU and Codex limits confirm this FAO 25% estimate (Eskola et al. 2020). However, this figure greatly underestimates the occurrence above the detectable levels (up to 60–80%). The high occurrence is likely explained by a combination of the improved sensitivity of analytical methods and the impact of climate change.
Globally, in terms of protection of human and animal health, aflatoxins are considered to be the most important mycotoxins (Marshall et al. 2020). Aflatoxin was the first mycotoxin to be discovered in the 1960’s (Bennett and Klich 2003; Richard 2008) and is the most well studied. Aflatoxins are carcinogenic, immunogenic and teratogenic to humans and animals (Marshall et al. 2020). They have also been linked with reduced immunity, reduced fertility and possible stunting in children (IARC 2012a). With 821 million people worldwide suffering from chronic undernourishment (UN 2019) and reports of the impact of aflatoxins on stunting of children in Africa (IARC 2015; Matacic 2016), the significant food and feed losses due to mycotoxin contamination further exacerbate the situation in developing countries and particularly in Sub-Sahara Africa.
Aflatoxins are predominantly produced by Aspergillus flavus and Aspergillus parasiticus, although other species such as Aspergillus australis may be important in a few southern hemisphere countries (IARC 2002). Aspergillus spp. are most abundant between latitudes 26° to 35° north or south of the equator, and therefore are commonly found in subtropical and tropical climates as opposed to more temperate areas of the world (CAST 2003; Wilson et al. 2002). Although aflatoxins in peanuts are limited primarily to pre-harvest infections, post-harvest contamination also can occur if Aspergillus infection is present and proper storage conditions are not maintained (Haerani et al. 2020). Depending on the environmental conditions, a wide range of mitigation strategies to reduce contamination levels in crops may be required. Aspergillus flavus can grow over a wide range of temperatures, (19–35 °C), with optimal growth and aflatoxin production occurring at 28 °C and 28–30 °C, respectively. Moreover, this fungal species has the ability to grow under conditions of low water activity (0.73 aw) and produce aflatoxins at 0.85 aw (Magan et al. 2011), therefore pre-harvest aflatoxin contamination is supported if temperatures are above average and rainfall is low, i.e. drought stress (Bennett and Klich 2003; CAST 2003).
However, aflatoxins pose a greater challenge when crops are stored under poor conditions that favour the growth of moulds (Bennett and Klich 2003; CAST 2003). This demonstrates the ongoing challenge and gravity of the problem and that effective mitigation strategies may reduce contamination, but never eradicate the problem altogether (Wilson et al. 2002). The commodities frequently contaminated with aflatoxins include; peanuts and peanut products, maize, wheat, rice, tree nuts, cottonseed, copra, seeds, milk, eggs, cheese and figs (Wilson et al. 2002; CAST 2003). There are approximately 20 structurally related compounds, of which aflatoxin B1, B2, G1 and G2, (AFB1, AFB2, AFG1 and AFG2) are the major metabolites associated with human and animal disease (Wu et al. 2013). Aflatoxins B1, B2, G1, and G2, are commonly found in tree nuts, peanuts and maize. Additionally, through consumption of contaminated feed, lactating animals have the ability to metabolise aflatoxin B1 to aflatoxin M1 and M2 and therefore present a risk to humans, particularly infants and children (Bennett and Klich 2003).
Aflatoxins not only pose serious, debilitating health threats to humans and animals alike, they also present significant economic concerns that invariably impact trade and the marketing of food commodities and feed (CAST 2003). Economic losses, as a direct consequence of aflatoxin contamination of crops, are almost impossible to estimate precisely (EC 1994). But total costs of mycotoxin contamination due to reduced yields, food and feed losses and increased costs for inspection and analyses may easily reach billions of Euro annually (Wu and Munkvold 2008). Costs will arise from human aflatoxicosis placing a burden on health care resources; losses in livestock value due to mortality and chronic illness; costs related to mitigation strategies and regulatory standards; the extent, level and variability of contamination and price fluctuations incurred because of crop quality and quantity (EC 1994; CAST 2003). In spite of a range of strategies to limit/mitigate crop contamination, mycotoxins, including aflatoxins, will continue to and increasingly pose safety risks to humans and animals (Eskola et al. 2020).
Although there is a huge body of literature concerning the main drivers for the development of food safety standards in relation to aflatoxins, the criteria and the data used, how do these decisions impact economically in terms of health and trade?
The aim of this study was to (a) elucidate the main drivers, criteria and sources of evidence, used to assist in food safety standards decision-making, (b) ascertain the economic impacts of these standards and c) to identify knowledge or evidence gaps. As one of the principal trading commodities often contaminated with aflatoxins, peanuts and peanut products were the focus of this case study.
Methods
The Campbell Methods Guide (Kugley et al. 2017) was followed for the retrieval of information for the systematic review. The PRISMA Extension for Reviews checklist (Tricco et al. 2018) was followed to elucidate the main drivers, criteria and sources of evidence used to assist in food safety standards decision-making and ascertain, not only, the economic impact of these regulatory guidelines but highlight important knowledge gaps. Relevant articles were initially identified using title and abstract screening and secondly by full text. The records were double screened by two researchers and any discrepancies settled by a third researcher. All citations were exported to EndNote and duplicates removed prior to full text screening. The screening results have been presented in a modified PRISMA chart.
Research Aims
This review aimed to:
-
1.
Elucidate the main drivers in developing food safety standards for aflatoxins in peanuts and peanut products.
-
2.
Define the main criteria used to develop these food standards.
-
3.
Highlight the sources of evidence/data used to develop these food standards.
-
4.
Ascertain the economic impact of these regulatory standards.
-
5.
Expose knowledge or evidence gaps.
Search Strategy
A systematic review of peer-reviewed and grey literature was conducted to understand the different contexts/settings/levels of decision-making and the main actors within food safety that support the decision-making. Electronic searches of the following databases were conducted: Scopus, Web of Science and PubMed. The following keywords and search strings were applied to the electronic literature databases outlined previously. These key search terms were also used to search for grey literature. This was piloted in Scopus.
(Aflatoxin*) AND (food*) AND (safety OR regulation* OR guideline* OR legislation OR standard* OR stakeholder* OR risk management OR risk assessment OR policy* OR economy* OR market* OR consumers OR impact OR products OR HACCP).
In addition, Google search engine was interrogated to identify relevant international and government agencies associated with food safety regulations for aflatoxins and identify additional grey literature relating to the topic. Specific grey literature sources included (not an exhaustive list):
-
a.
European Commission
-
b.
European Food Safety Authority
-
c.
World Health Organisation/Food and Agriculture Organization of the United Nations/The Joint FAO/WHO Expert Committee on Food Additives (JECFA)/The International Food Safety Authorities Network (INFOSAN)/The Codex Alimentarius Commission (CAC)
-
d.
US Food & Drug Administration (FDA)
-
e.
China National Centre for Food Safety Risk Assessment (CFSA)
-
f.
The Food Standards Australia New Zealand (FSANZ)
-
g.
The Food Safety and Standards Authority of India
-
h.
The National Food Safety Standards System, China
-
i.
Food Standards Agency
-
j.
Industry Reports
-
k.
The Rapid Alert System for Food and Feed
Inclusion Criteria
Studies were identified by searching literature published in English only between inception of the databases and June 2021. These dates are particularly relevant to aflatoxins as they were discovered in the 1960’s, hence data has been available for decades. No restrictions were placed on geographical regions and no particular study design was specified. The search strategy was piloted to test the suitability of the electronic databases and the selected keywords.
Exclusion Criteria
Any publications relevant to other mycotoxins such as deoxynivalenol, fumonisins, T-2 toxin, HT-2 toxin, zearalenone, ochratoxin, masked mycotoxins and emerging mycotoxins were excluded. Conference proceedings, in vitro and animal studies were excluded. All duplicates were removed.
Critical Appraisal
Critical appraisal of the publications ensured that only relevant high quality studies were included in the review and low quality studies excluded. This step was based on the Critical Appraisal Skills Programme (CASP) Tools Checklists (CASP 2018). To be included in the review, papers had to adequately answer the following citation, title and abstract screening questions:
-
1.
Does the citation indication publication within the time period specified?
-
2.
Is the title and abstract in English?
-
3.
Aim of study?
-
4.
What were the main findings of the paper?
-
5.
Strengths?
-
6.
Limitations?
-
7.
Did the author acknowledge any limitations?
-
8.
Were the findings consistent with other literature?
The studies were classified using keywords signifying their relevance to the five research aims described previously and further questions considered. In terms of the main drivers to developing food standards for aflatoxins in peanuts, the following were examined. Evidence regarding the scale of contamination and the risks to consumers; worldwide peanut production including the largest exporters; the impacts on human and animal health and how climate change is expected to affect the production of aflatoxins in peanut producing regions of the world. In defining the main criteria used to develop these food standards it was crucial that the procedures relating to risk analysis, risk management and risk communications were described. Were different approaches used, thus resulting in different maximum levels? In relation to the data used in the development of the safety standards, information such as toxicological data, food consumption data, availability of occurrence data in various commodities, knowledge of the distribution of contaminant concentrations within a lot, availability of analytical methods, legislation in countries where trade contacts exist and the need for sufficient food supply were required. For the economic impact of the legislation, the impact of trade and health were considered.
Synthesis of Information
A narrative synthesis of the extracted data was conducted, in order to address the aims of the review and to facilitate the inclusion of both qualitative and quantitative data. Scientific publications and grey literature were collated to provide an overview of the main drivers in developing food safety standards for aflatoxins, to define the main criteria used to develop food safety standards, to highlight the sources of evidence/data used to develop these food standards and to ascertain the economic impact of these regulatory standards.
Literature Search Results
Using the described search strategy, 2671 references were retrieved and subjected to screening and critical appraisal. Both qualitative and quantitative studies were included in the review. Overall, 60 papers passed the critical appraisal process and were included. A summary of the critical appraisal approach has been detailed in Online Resource 1 and Fig. 1 summarises this procedure.
Results of the grey literature search have been outlined in Online Resource 2. Sources of information retrieved included international and government agency websites, providing legislative documents, reports, guidelines, and standards.
Effect of Aflatoxins on Human and Animal Health
Aflatoxins are hepatotoxins, as they primarily target the liver and are considered some of the most recognised potent substances, in terms of mutagenicity and carcinogenicity (Eskola et al. 2020). The toxicological properties of these compounds are extremely well recognised and AFB1, AFB2, AFG1, AFG2 and AFM1 were classified as Group 1 human carcinogens by the International Agency for Research on Cancer (IARC) in 2012 (IARC 2012b). The evidence for aflatoxins causing hepatocellular cancer was established through decades of epidemiological studies revealing that the aflatoxin metabolites are enzymatically converted to reactive epoxide metabolites on entering the liver. They then further react to form DNA adducts and the tumour p53 gene undergoes mutation. Subsequently, the aflatoxin-N7-guanine adduct is excreted in the urine. Other serum adducts such as AFB1-lysine and AFB1-albumin are also formed. Through measurement of these biomarkers in urine and blood, and additional evidence showing that in areas with high incidences of hepatocellular cancer (HCC), approximately 50% of tumours contained a mutation in the tumour p53 gene; the causal link to HCC was proven (IARC 2012b). In addition, in populations where the hepatitis B virus is endemic, the risk of HCC caused by aflatoxins increases up to 30 times than that in uninfected populations (IARC 2012b). Recently, it has also been revealed that AFB1 exposure increases the risk of hepatocellular carcinoma associated with hepatitis C virus infection or alcohol consumption (Chu et al. 2018). Moreover, chronic exposure to aflatoxins has been associated with stunting in children in West Africa and studies on immunomodulation have suggested that populations chronically exposed to aflatoxins may be more susceptible to aflatoxicosis and cancer. However, further research is required to uncover the mechanism by which aflatoxins may affect child growth and, as yet, there is not enough information to conclude that aflatoxin exposure affects human immunity resulting in greater susceptibility to disease (IARC 2012a). Acute aflatoxicosis has also been demonstrated in humans. In 1974, an Indian outbreak of acute hepatitis in which the mortality rate was 25%, was deemed to be due to the consumption of maize, highly contaminated with aflatoxin and indeed liver samples from those that died, contained detectable concentrations of AFB1. Two other human diseases have also been linked to the consumption of food contaminated with aflatoxin, namely Kwashiorkor, a paediatric malnutrition disease and Reye’s syndrome, that presents as encephalopathy and fatty degeneration of the viscera in children, although the aetiology has not been defined (CAST 2003; Bennett and Klich 2003).
Furthermore, aflatoxins are acutely toxic, mutagenic, teratogenic and carcinogenic to most animal species and have been ranked; AFB1 > AFG1 > AFB2 > AFG2 in terms of their toxicity (EC 1994). Clinical manifestations of chronic aflatoxicosis have been reported as reduced weight gain in cattle, pigs and poultry, reduced feed intake and feed conversion in pigs and poultry, reduced milk yields in cows, immunosuppression and decreased egg production in poultry (CAST 2003; Diaz 2005; EC 1994). Acute exposure leads to necrosis of the liver and eventual death (EC 1994; CAST 2003). However, it is the chronic exposure in animals that carries the greatest economic burden when compared to acute animal death (CAST 2003).
Effect of Climate Change on Aflatoxin Production
Climate change is widely accepted and rises in temperature, increased precipitation and carbon dioxide levels and drought will all have a significant effect on food security (Marroquín-Cardona et al. 2014). Furthermore, it is expected that developing countries will bear the greatest impact compared with developed countries (Wambui et al. 2016). As described, the most important factors affecting fungal growth are moisture and temperature, however other factors including inoculum concentrations, microbial interactions, insect infestation, physical damage, availability of nutrients and carbon dioxide levels will promote infection and contamination (CAST 2003). Climate change has and will undoubtedly have a greater effect on the growth and distribution of mycotoxigenic fungi and the mycotoxins subsequently produced. Hot, dry conditions that exacerbate plant stress will increase the contamination of food and feed with aflatoxins (Medina et al. 2017). Therefore, aflatoxins will continue to grow in importance in terms of being one of the greatest threats not only to food safety but also to livestock production (Wu and Mitchell 2016). Few studies have concentrated on the impact of climate change on aflatoxin contamination of peanuts. Generally, the focus has been on maize, however this information is useful in determining the growth and distribution of the toxigenic strains. In Kenya, it has been estimated that there may be a 59% increase in aflatoxin contamination levels in central and western parts due to increasing temperatures, whereas in eastern and southern regions, contamination will decrease by approximately 45% (Wambui et al. 2016). Other studies researching the potential influence of climate change on aflatoxins in maize in the USA (Wu et al. 2010) and in Malawi (Warnatzsch et al. 2020), concluded that greater contamination with aflatoxins is the likely scenario in the future. Another study conducted on future distribution of aflatoxins in peanuts in Australia indicated that a shift in toxin production from eastern areas to the southeast and southwest of Australia would occur by 2100. While only a small area of Australia would present the optimal climate conditions for the production of aflatoxins, this included the current peanut producing areas (Haerani et al. 2020).
Furthermore, quantitative research in Europe has also predicted increased aflatoxin contamination of maize in the future, under the + 2 °C climate scenario (Van Der Fels-Klerx et al. 2016). This research group identified several research gaps with respect to predicting the impact of climate change on aflatoxin occurrence, such as advances in quantitative modelling have been limited and their application to different crops and different regions of the world, while paramount to predicting the impact of climate change on aflatoxins contamination, is severely lacking (Van Der Fels-Klerx et al. 2016). Moreover, the involvement of developing countries in predictive modelling is needed, as very often these are the countries most affected by aflatoxin contamination of crops. While contamination levels of mycotoxins vary from one year to the next depending on the climatic conditions, with climate change it is expected that the occurrence of mycotoxins in crops will increase and the geographical distribution of pathogenic fungi and consequently mycotoxin occurrence patterns will be both enlarged and altered in pattern (Marroquín-Cardona et al. 2014; Wu and Mitchell 2016). Therefore, the importance of crop management, adaptation and mitigation strategies will become increasingly important in the drive to reduce aflatoxins in foods, particularly in developing countries (Marroquín-Cardona et al. 2014; Wambui et al. 2016; Wu and Mitchell 2016).
Increased economic costs resulting from climate change are expected. The effects will not only be observed at the producer/handler level, with crop rejections, increased production costs, particularly for irrigation and increased monitoring and testing but also in terms of reduced animal productivity and greater risks for human health. Aflatoxin contamination will vary year on year, depending on weather patterns, therefore it is very difficult to estimate the economic costs that may be incurred (Wu and Mitchell 2016).
World Peanut Production
Peanuts, also known as groundnuts are the fruits of legumes. They originated in South America but are now cultivated in Africa, Asia and North America for the global market (Chang et al. 2013). Originally, peanuts were used primarily for animal feed, however, nowadays the market for products for human consumption is immense. They can be consumed whole, roasted or used for other products such as peanut butter, peanut oil, confectionary, baked goods, breakfast cereals and many sauces and dressings (Chang et al. 2013). They are a rich source of protein, fibre, fats, minerals and vitamins (Norlia et al. 2019) and consumed as part of the diet, have been linked to lower body mass index (BMI) (Chang et al. 2013). In terms of animal feed, peanut meal is a highly palatable and excellent source of nutrition used extensively for beef cattle and poultry and in aquaculture. Driven by the increasing demand for meat and seafood, the compound annual growth rate for this market has been estimated at 4.5% over the period 2022 to 2027. Currently North American enjoys the largest market while the Asia Pacific market is growing rapidly (MordorIntelligence 2021).
Groundnuts are well suited to and grown extensively in subtropical and tropical countries (Norlia et al. 2019). China is the world’s major peanut producer, producing an estimated 18 million metric tonnes per annum (FAOSTAT 2019), approximately 40% of global total production. Cultivation of the finest crop generally takes place in the provinces of Jiangsu, Shandon, Hebei, Guangdong and Henan (Basicplanet 2021). After China, in terms of metric tonne production per annum, the ranking is as follows: India > Nigeria > Sudan > United States of America > Myanmar > Senegal > Argentina > Guinea > Chad, accounting for in the region of 83% of the world’s total production (FAOSTAT 2019) (Fig. 2). Broken down by region, in 2019, Asia produced the greatest quantity of peanuts (56%), followed by Africa (34%) and the Americas (10%) (FAOSTAT 2019).
Chart outlining the top ten countries for peanut production in terms of metric tonnes. Included is the tonnage as a percentage of the total peanut production for 2019. Data from the Food and Agriculture Organization Corporate Statistical Database (FAOSTAT 2019)
Rapid Alert System for Food and Feed
Aflatoxins contaminate many different food commodities such as peanuts, maize, wheat, rice, tree nuts, cottonseed, copra, nuts, milk, eggs, cheese, figs and other fruits, chilli and other spices (CAST 2003). Therefore, it is important to ascertain which products pose the greatest risk to consumer health. To get a sense of this, the European Union Rapid Alert System for Food and Feed (RASFF), (EU 2021) is an important resource. RASFF is large database that provides data relating to all food safety notifications for imported goods into the EU. This information is disseminated to European Economic Area (EEA) countries and Switzerland to protect public health. Notifications/alerts were analysed for the years, 01 January 2016 until 31 December 2020, to determine the commodity posing the greatest risk to consumers in terms of aflatoxin contamination. This information was sourced from FOODAKAI, the food risk prediction platform, Agroknow (FOODAKAI 2021). Of the 2341 alerts notified within the EU for that period, due to aflatoxins, 1768 were attributable to aflatoxins in nuts, nut products and seeds (Fig. 3), accounting for 75.5% of the notifications in all product categories. More specifically, the number of notifications for peanuts amounted to 657, (37.2%), within the specific product category.
EU RASFF Alerts for aflatoxins per commodity from 01 January 2016 until 31 December 2020. Data from FOODAKAI, the food risk prediction platform, Agroknow (FOODAKAI 2021)
Moreover, in terms of the total notifications for aflatoxins per country of origin during the selected period, the breakdown is shown in Fig. 4. The greatest number of alerts came from products from Turkey (22.21%). Out of the 525 notifications, 53.4% were due to nuts, nut products and seeds but only 2.8% attributed to peanuts. It is interesting to note that the percentage of alerts for products originating from the USA, China and India, were 13.37%, 9.09% and 7.28%, respectively. These countries fall within the top peanut producing countries of the world, illustrated in the previous section (World peanut production).
From the data, it is clear that peanuts provide the greatest risk to European consumers in terms of contamination with aflatoxins, thereby emphasising the importance of peanuts and their products in terms of food safety, within the EU.
Legislative Framework
Concerns over food safety and quality stem back hundreds of years, however with advancements in science, statutory regulations enforced by many countries eventually culminated in the establishment of official legislation and regulations (Van Egmond and Jonker 2004). While these legislative standards prohibit the adulteration and mislabelling of foodstuffs, the motivation at international and national level has been the protection of consumers from chemical and microbiological hazards. Among the chemical contaminants are those that are naturally occurring, such as mycotoxins, phytotoxins and phycotoxins; many of which are known to have serious effects on the health of humans and animals (FAO/WHO 2004). As such, limits on the permitted concentrations of some of these toxins in foods have been established to protect human and animal health. Among the natural toxins, mycotoxins are the most heavily regulated throughout the globe. Initially, only the more developed countries had enforced legislative limits, however through time the number of countries adopting specific regulations or detailed guidelines for mycotoxins in food had grown from 33 (1981), to 100 (2003), (covering approximately 85% of the world’s inhabitants) with aflatoxins having been included from the beginning (Van Egmond and Jonker 2004; Van Egmond et al. 2007).
The regulations for aflatoxins in peanuts and peanut-based products vary throughout regions of the world, however the exponential growth of the international trade in foods and feeds, ingredients and raw materials used in food production have necessitated international legislative standards to protect consumers and ensure fair trade. Each year, billions of tonnes of food is produced, marketed and transported; estimated at 2000 billion dollars a year (FAO/WHO 2021).
Codex Alimentarius Commission Legislation
Globally, the joint Food and Agricultural Organisation of the United Nations/World Health Organisation (FAO/WHO) food standards programme known as the Codex Alimentarius Commission (CAC), is responsible for the development of this legislation (Eskola et al. 2020; Berg 2003). Not only do they provide standards for raw, semi-processed and processed foods for consumers; sampling plans and methods of analysis are also included within these guidelines. Overall risk management is the responsibility of the Codex Committee for Contaminants in Foods (CCCF), who recommend proposals for implementation by CAC. They will set or revise maximum permitted levels for contaminants in foods and feeds, prioritise risk assessments, develop sampling plans, methods of analysis, standards or codes of practice and other matters related to contaminants and natural toxins in food and feed (CAC 2013). In terms of risk analysis, it is the Joint FAO/WHO Expert Committee on Food Additives (JECFA) that perform these evaluations, scientifically assessing the available toxicological and exposure evidence for each contaminant. Ultimately, these evaluations inform the decision-making process by CCCF and CAC. The Codex General Standard for Contaminants and Toxins in Food and Feed (GSCTFF), (CAC 1995), outlines the principles adopted by CAC in dealing with contaminants and natural toxins in food and feed. CAC defines a contaminant as “any substance not intentionally added to food or feed for food producing animals, which is present in such food or feed as a result of the production (including operations carried out in crop husbandry, animal husbandry and veterinary medicine), manufacture, processing, preparation, treatment, packing, packaging, transport or holding of such food or feed, or as a result of environmental contamination”. The standard also clearly states, “Maximum Levels, (MLs), shall only be set for food in which the contaminant may be found in amounts that are significant for the total exposure of the consumer. The maximum levels shall be set in such a way that the consumer is adequately protected. At the same time, the other legitimate factors need to be considered. Maximum levels shall be based on sound scientific principles leading to levels, which are acceptable worldwide, so that there is no unjustified barrier to international trade. MLs shall be clearly defined with respect to status and intended use”. “The Codex maximum level (ML) for a contaminant in a food or feed commodity is the maximum concentration of that substance recommended by the Codex Alimentarius Commission to be legally permitted in that commodity” (CAC 1995). The food safety standards, guidelines and recommendations for food additives, veterinary drug and pesticide residues, contaminants, methods of analysis and sampling, and codes and guidelines of hygienic practice established by the CAC have been recognised and incorporated into the World Trade Organisation’s Agreement on the Application of Sanitary and Phytosanitary measures (WTO 1995). Thus, in the event of international trade disputes, these documents support settlement. Maximum limits for the sum of AFB1, AFB2, AFG1 and AFG2 in various commodities, including peanuts are detailed in the aforementioned food safety standard along with recommended sampling plans for these products (CAC 1995).
European Union Legislation
In the European Union, legislation is established under a very similar process, the basic principles of which are defined in Council Regulation (EEC) No 315/93 (EC 1993). Not only does the European Commission (EC) establish maximum permitted limits for specific contaminants, they often establish limits for the same contaminants in different foods, they will stipulate analytical detection limits and may require adoption of guidance on the sampling procedures or analytical methods to be used. Risk management is the responsibility of the Directorate-General for Health and Food Safety (DG SANTE) who implement European Union laws on the safety of food and other products, on consumers' rights and on the protection of people's health. Formerly, risk assessment was performed for the EC by the Scientific Committee on Food (SCF), established in 1974, but in 2002, its responsibilities were transferred to the European Food Safety Authority, (EFSA), (Eskola et al. 2018). EFSA’s Scientific Committee (SC) is responsible for the development and harmonisation of many scientific themes, coordinates the scientific opinions prepared by the different EFSA Scientific Panels and offers scientific advice to EFSA’s management. Regarding scientific opinions on mycotoxins, depending on the request, different scientific panels may be involved. These include the EFSA Panels on Contaminants in the Food Chain (CONTAM Panel), EFSA Panel on Additives and Products or Substances used in Animal Feed (FEEDAP Panel), the EFSA Panel on Plant health, the EFSA Unit on Evidence Management (DATA) or indeed the EFSA SC and the Emerging Risks Unit (Eskola et al. 2018). To develop the risk assessments, the CONTAM panel, evaluates toxicokinetic and toxicity data in experimental animals, farm and companion animals and humans, analytical methods and available occurrence data for the contaminants in food and feeds as well as examining any existing risk assessments (Eskola et al. 2018). Originally, Commission Regulation (EC) No 1525/98 laid down MLs for contaminants in foodstuffs, including aflatoxins and detailed the directives relating to both sampling methods and the performance criteria for methods of analysis (EC 1998). This regulation was replaced by Commission Regulation (EC) No 466/2001 and more recently by Commission Regulation (EC) No 1881/2006 (EC 2001, 2006), taking into account new information and developments in Codex Alimentarius.
Legislation in Other Countries
Other countries/regions have adopted their own aflatoxins legislation. In the United States of America, (USA), the US Food and Drug Administration, (US FDA), have issued a Compliance Policy Guide for Aflatoxins in Peanuts and Peanut Products, Sec. 570.375, (FDA 1980) and in Canada, the Canadian Food Inspection Agency, (CFIA), has established regulations for levels of aflatoxins in food and feeds (CFIA 2017). In Australia and New Zealand, it is the Food Standards Australia New Zealand (FSANZ), that has instituted MLs for aflatoxins in peanuts under Schedule 19: Maximum levels of contaminants and natural toxicants (FSANZ 2017). In 2011, the Food Safety and Standards Authority of India (FSSAI), introduced the Food Safety and Standards (Contaminants, toxins and Residues) Regulations (F. No. 3/15015/30/2011), detailing MLs for aflatoxins in all foods (FSSAI 2011). In China, the National Health and Family Planning Commission (NHFPC) and the China Food and Drug Administration (CFDA), released the National Food Safety Standard of Maximum Levels of Mycotoxin in Foods, which details a ML for AFB1 in peanut and its products (USDA 2018). Japan’s Food and Agricultural Materials Inspection Centre (FAMIC), has listed regulatory limits for AFB1 in all foods (FAMIC 2011), meanwhile MERCOSUR, a free trade zone made up of Argentina, Brazil, Paraguay, Uruguay and Venezuela have adopted harmonised MLs for aflatoxins in peanuts and peanut products (FAO/WHO 2004).
Disparity of Maximum Limits for Peanuts
The MLs implemented globally by the CAC and by other trading regions and countries have been detailed in Table 1, highlighting the differences throughout the world. It is evident that countries having the greatest problems with aflatoxin contamination very often have less stringent standards or none at all (Sirma et al. 2018). All MLs are established on the basis that Good Agricultural Practice (GAP) and Good Manufacturing Practice (GMP) are adopted to control contamination at a level as low as reasonably achievable (ALARA) to protect the consumer. Furthermore, recognition that physical treatments and sorting can reduce the contamination levels in peanuts, higher MLs for peanuts requiring further processing have been adopted in a bid to minimise effects on trade.
In 1995, CAC imposed an ML of 15 µg/kg for total aflatoxins (AFB1, AFB2, AFG1 and AFG2) in peanuts intended for further processing (FP) (CAC 1995) and in 1998, the EU imposed stricter MLs for AFB1 and total aflatoxins in ready to eat (RTE) peanuts of 2 µg/kg and 4 µg/kg, respectively. For unprocessed peanuts, MLs of 8 µg/kg and 15 µg/kg for AFB1 and total aflatoxins, respectively, were introduced (EC 2006). Higher peanut MLs have been imposed for total aflatoxins in the USA (20 µg/kg) (FDA 1980), in the MERCUSOR countries (20 µg/kg) (FAO/WHO 2004) and in India (30 µg/kg) (FSSAI 2011), while in Africa, eleven countries had MLs for peanuts and peanut products, ranging from 1 to 20 µg/kg for AFB1 and 10 µg/kg to 20 µg/kg for total aflatoxins (FAO/WHO 2004). In terms of peanut production in Africa, 46 out of the 54 countries grow and harvest this crop. The top ten producers are shown in Fig. 5. Of these, four have implemented regulatory limits for aflatoxins. These are as follows; a ML of 20 µg/kg for AFB1 in food in Nigeria, Codex regulations are followed in Sudan with respect to oilseeds (15 µg/kg), in Tanzania MLs of 5 µg/kg and 10 µg/kg for AFB1 and total aflatoxins exist for food and feed while in Senegal, MLs of 50 µg/kg and 300 µg/kg have been applied to AFB1 in feedstuffs and feedstuff ingredients, respectively, but no regulations exist for food (FAO/WHO 2004).
Chart outlining the top ten African countries for peanut production in terms of metric tonnes. Included is the tonnage as a percentage of the total peanut production for 2019. Data from the Food and Agriculture Organization Corporate Statistical Database (FAOSTAT 2019)
This demonstrates that although aflatoxin exposure is a major issue in the context of food safety (Shephard 2003), the majority of African countries do not have aflatoxin regulations for peanuts and peanut products and even in those that have introduced legislative limits, contamination levels still exceed these and therefore present a risk to consumers (Udomkun et al. 2017; Shephard 2008). If MLs were created for peanuts in these countries, would this improve health protection? Given the heavy reliance on subsistence farming, food insecurity is a constant threat to the population due to the climatic conditions, so no matter what the quality of the food produced, what choice does the population have? (Ladeira et al. 2017; Matumba et al. 2017; Shephard 2003). This highlights the trade-off between food security and food safety in such regions of the world.
In Asia, the setting of aflatoxin regulations in peanuts and peanut products has become a priority. Countries such as China, Hong Kong, Indonesia, Malaysia, Philippines, Singapore, Sri Lanka, Taiwan, Thailand and Vietnam have established their own standards, none of which are harmonised at present. However, the Association of Southeast Asian Nations (ASEAN) Reference Testing Laboratories (ARLs) have been established in Malaysia, Singapore, Thailand, and Vietnam for food-borne contaminants and may result in the adoption of harmonised standards as these currently sit at 35 µg/kg, 5 µg/kg, 20 µg/kg and 10 µg/kg, respectively for total aflatoxins (Anukul et al. 2013).
Establishment of Legislative Limits
From the literature, it is evident that the regulations for aflatoxins in peanuts and peanut products are not harmonised throughout the world. This is because different criteria are taken into account when creating the legislation, however the procedures involved in risk analysis for any food contaminant follow very similar approaches and are illustrated in Fig. 6.
Risk Assessment (CAC and EU)
Risk analysis of aflatoxins (and indeed all contaminants), includes the assessment of toxicological data, exposure data, knowledge of the concentrations in commodities or lots, what analytical methodologies are available, legislation adopted by trading partners and the need for food security (Van Egmond et al. 2007).
Hazard identification and characterisation form the scientific basis for the creation of MLs for contaminants in foods and involve the evaluation of the probability that adverse health effects will result from human exposure to these food-borne hazards (Berg 2003; Van Egmond et al. 2007). This is known as risk assessment and is performed by JECFA and EFSA on behalf of CAC and the EU Commission, respectively. For most contaminants, the risk characterisation results in the determination of an acceptable daily intake (ADI) or tolerable daily intake (TDI) calculated from a no observed adverse effect level (NOAEL) derived from animal studies and the application of an uncertainty factor (O'Brien et al. 2006). However, as aflatoxins are genotoxic carcinogens, the typical hazard assessment procedures are not applicable. Therefore, the assumption is that there is no safe dose and so enforcing legislation that prohibits any concentrations of aflatoxins in food would be fitting. However, these are natural toxins and are impossible to eliminate completely in the food supply chain. In this instance, both JECFA and SCF adopted the ALARA principle (Giorgi and Tandon 2010; Van Egmond and Jonker 2004). Moreover, to complete the hazard characterisation, rather than using ADI or TDI, identification of reference points of the dose–response data to characterise the risks of exposure for humans are used (Eskola et al. 2018). The more common reference points used by EFSA and JECFA is the benchmark dose (BMD) and the BMD lower confidence limit (BMDL). To calculate health based guidance values (HBGVs), uncertainty factors or a margin of exposure (MOE) are applied between the BMDL and the estimated dietary exposure (Eskola et al. 2018; FAO/WHO 2005) and both EFSA and JECFA agreed on the adoption of the margin of exposure (MOE) method (EFSA 2005; FAO/WHO 2005). Following this, an international conference organised by EFSA and WHO with support from the International Life Sciences Institute, European Branch (ILSI Europe) was held to discuss and develop a possible common approach to the risk assessment of genotoxic and carcinogenic food hazards (Barlow et al. 2006). The consensus was that ALARA, (a qualitative approach), provides no information on the potency of a particular carcinogen and the extent of human exposure is not taken into account (Barlow et al. 2006; O'Brien et al. 2006). The authors concluded that the quantitative method of linear extrapolation of animal dose–response data from bioassays raised uncertainties, depending on the mathematical models used, however they all agreed that the best approach was the margin of exposure (MOE), that uses experimental animal data, human epidemiological data (if available), and does not rely on extrapolation and mathematical models (Barlow et al. 2006).
The third step of the risk assessment process is exposure assessment and involves estimating what concentrations of contaminant, how often, and over what period of time humans or animals are exposed to the hazard (IARC 2012a). This stage relies heavily on reliable data for the level of contamination in foods and food intake assessments. However, this has been challenging in the past due to inadequate data for the occurrence of aflatoxins in foods and dietary recall is particularly inaccurate (IARC 2012a; FAO/WHO 2004). The introduction of the Global Environment Monitoring System—Food Contamination Monitoring and Assessment Programme (GEMS/Food) and its web-based system, GEMS/Food contaminants database established in 2011 (WHO 2021) in addition to the Scientific Cooperation on Questions relating to Food (SCOOP), set up by the EC have improved the reliability of data used for exposure assessments. Furthermore, the ability to measure validated biomarkers in urine and serum for aflatoxin exposure in human populations has significantly supported epidemiological studies (IARC 2012a).
For analysis, sampling procedures are crucial. The distribution of aflatoxins, particularly in peanuts can be very heterogeneous, therefore to ensure an accurate measurement of the concentration, great care must be taken in obtaining a representative sample from the lot/batch (Van Egmond et al. 2007). As a result, detailed sampling procedures have been instituted by CAC, the EU and the FDA (CAC 1995; EU 2010; FDA 2021) and incorporated into the standards or guidance documents.
Throughout the world, monitoring of aflatoxins in foods to ascertain regulatory compliance and the quality of foods is performed by official control laboratories, the food industry and research institutions (Eskola et al. 2020). Both screening and confirmatory methods exist for the detection and quantification of aflatoxins in peanuts and peanut products, many of which have been certified by the Association of Official Analytical Chemists (AOAC International), the European Standardisation Committee (CEN) and ISO (International Organisation for Standardisation). All AOAC methods are termed official methods as they have undergone rigorous validation and inter-laboratory studies prior to being reviewed and approved. The CEN methods meet the performance requirements laid down in the EU regulations for sampling and analysis of aflatoxins in peanuts (EC 2001), however they are not mandatory for official control within the EU (Van Egmond et al. 2007).
Typical methods of analysis range from chromatographic methods such as thin-layer chromatography (TLC), high performance liquid chromatography (HPLC) with fluorescence detection, liquid chromatography coupled to tandem mass spectrometry (LC–MS), spectroscopic techniques, for example, fluorescence spectrophotometry and infrared spectroscopy, in addition to the immunochemical methods of enzyme linked immunosorbent assay (ELISA) and lateral flow devices (Jallow et al. 2021).
The final stage of the risk assessment process is risk characterisation. Based on the hazard identification, hazard characterisation and exposure assessments, an estimation of the possible health risks for humans and animals is provided. This scientific opinion will emphasise the uncertainties identified for the risk assessments (Eskola et al. 2018; Huggett et al. 1998).
Risk Management (CAC and EU)
Risk management is the process of appraising different policies, following risk assessment outcomes. This entails implementation of regulatory measures and control options to ensure protection of public health but also control contamination (Berg 2003; Huggett et al. 1998). In addition to food safety concerns, “other legitimate factors” defined under risk management decision-making criteria have been adopted by CAC (CAC 2013). These include the costs associated with the establishment of MLs and the methods of analysis required, the feasibility of monitoring and enforcing MLs, consumer concerns associated with the safety of contaminants, variations in food consumption resulting from different traditions and regions and the importance of the food to the country of origin and international trade, (Berg 2003; Huggett et al. 1998). The incorporation of these factors “should not create unjustified barriers to trade; particular attention should be given to the impact on developing countries of the inclusion of such other factors” (CAC 2013). A similar set of criteria are used by EU (Giorgi 2013). The driving force behind risk management procedures used by CAC are to determine levels of acceptable risk (Huggett et al. 1998), however in the EU, adherence to the Precautionary principle (EC 2002), allows implementation of risk management measures in the absence of conclusive scientific evidence (Giorgi and Tandon 2010). The final component in the risk analysis framework is risk communication, supporting the exchange of information and opinions among relevant stakeholders such as governments, industry, consumers, non-governmental organisations and academia (CAC 2013).
Risk Analysis in Other Countries
The procedures involved in risk assessment, risk management and risk communication by the US FDA follow the same set of criteria outlined above (Henry et al. 1993; Park and Stoloff 1989).
In Australia and New Zealand, FSANZ performed risk assessments for aflatoxins in peanuts by the same means described for CAC and MLs were only established where the justification was to maintain public health and safety (Abbott et al. 2003). The countries apply their regulatory activity only to the importation of high-risk foods, which includes aflatoxins in peanuts. For domestic food regulation, both countries have introduced a risk-based approach as opposed to regulatory compliance inspections, thus the onus for food safety is transferred from regulators to the food industry. Monitoring of foods is still performed by the regulatory authorities and while this surveillance can be used to check compliance, the focus has been for risk assessment (Cressey 2009).
Impact of Using Different Criteria for Risk Assessment
As stated previously, the adoption of different criteria when creating the legislative MLs often differ, resulting in establishment of divergent regulations. The following case illustrates the different criteria applied by JECFA and EFSA when assessing the impacts of different legislative standards for aflatoxins in peanuts and peanut products and the resulting disparity in scientific opinions that have been used to establish MLs by CAC and the EU. In 2017, JECFA were asked by the CCCF to consider the impact of establishing MLs for total aflatoxins in RTE peanuts at 4 µg/kg, 8 µg/kg, 10 µg/kg and 15 µg/kg. They concluded that enforcing MLs of 4 µg/kg, 8 µg/kg or 10 µg/kg would have little impact on dietary aflatoxin exposure in the general population, compared with a ML of 15 µg/kg, but that if the ML was set at 4 µg/kg, this would double the border rejections of RTE peanuts (20% at 4 µg/kg as opposed to 10% at an ML of 15 µg/kg) (FAO/WHO 2017). Following this, EFSA were asked to deliver a scientific opinion on the human health impact of increasing the ML of 4 µg/kg to 10 µg/kg for RTE peanuts and their products. They concluded that such an increase in the ML would increase the risk of cancer by a factor of 1.6–1.8 (Knutsen et al. 2018). The differences in the JECFA and EFSA opinions have been attributed to different methodologies used when considering exposure assessment. The CONTAM Panel limited the exposure assessment to RTE peanuts, peanut butter and processed peanut products, not taking into account other potential sources in the diet and the assessment was made for consumers only, whereas JECFA considered all food sources and the general population. Additionally, JECFA excluded all non-compliant samples (those exceeding the MLs of 4 µg/kg, 8 µg/kg, 10 µg/kg and 15 µg/kg). The CONTAM Panel had followed this approach previously, however, in this instance had included non-compliant samples as in reality, a small proportion of products in the market will exceed the regulatory limits. If they were not included in the assessment, this would result in an underestimation of the risk (Knutsen et al. 2018).
Economic Impact of the Different Regulatory Standards for Aflatoxins in Peanuts and Peanut Products
The economic impacts of regulatory standards for aflatoxins encompass many aspects. These take into account the costs incurred as a result of human disease, a reduction in marketable crops, reduced profits, non-conforming products resulting in trade rejections and the losses associated with reduced livestock productivity/morbidity. In addition, the costs required to implement and enforce regulatory standards and to research prevention, control and mitigation strategies must also be taken into consideration (Udomkun et al. 2017).
Impact of Regulatory Limits on Human Health
The human health impact of acute and chronic exposure to aflatoxins is extremely difficult to quantify. However, losses in developing countries will undoubtedly far exceed those of western societies due to the elevated contamination concentrations in food products, the lack of regulatory measures enforced and lack of knowledge on prevention and control of these mycotoxins (Matumba et al. 2017; Moretti et al. 2017). The most significant human health consequence of dietary exposure to aflatoxins is HCC. Hepatocellular carcinoma causes the death of approximately 250,000 people in Sub-Saharan Africa each year and this has been attributed to the high intake of aflatoxins in food in addition to the Hepatitis B virus (HBV) (Ladeira et al. 2017). Actually, it has been estimated that due to the contamination levels of aflatoxins in food, the prevalence of HBV and population density, exposure to aflatoxins have contributed to 25,200–155,000 (4.6–28.2%) HCC cases annually on a global scale, with the vast majority occurring in Sub-Saharan Africa, South-East Asia, and China (IARC 2012a; Mamo et al. 2020). However, in contrast, in Japan, it was revealed, based on a 3-year exposure assessment study, that the population risk of HCC was extremely low. Hence the current standards are protective of human health (Sugita-Konishi et al. 2010).
Of particular importance is the exposure of children and infants to aflatoxins. This begins at an early stage through breast milk (if the mother is susceptible to dietary exposure), from contaminated weaning products and food products (Mamo et al. 2020). Evidence has shown that exposure to aflatoxins in this demographic has resulted in growth impairment and poor immune status (Gong et al. 2004; Khlangwiset et al. 2011; Mupunga et al. 2017). Moreover, there have been suggestions that dietary exposure to aflatoxins may play a causal role in the development of Kwashiorkor, although the mechanism is unclear (Khlangwiset et al. 2011; Mupunga et al. 2017). In Sub-Saharan Africa, peanuts and peanut products are commonly used in weaning foods for infants and children and although, maize is generally the primary commodity used for these purposes, peanuts and their products must not be ignored as they will undoubtedly contribute to the overall health burden and disease in children. Despite the evidence of the damaging effects of aflatoxins on public health, this has not been addressed even with rising cases of liver cancer and growth impairment in children (Ladeira et al. 2017).
In Africa and Asia there is a serious lack of relevant information thus making reliable exposure risk assessment and risk management of mycotoxins challenging (Anukul et al. 2013; Songsermsakul 2015; Meijer et al. 2021). Hence, the human health impact of aflatoxins has not been investigated. The situation in South America is similar to that of African or Asian countries with the highest quality commodities being exported internationally, leaving the poorer quality foods for internal consumption (Scussel 2004). While standards have been adopted by Brazil, Argentina, Paraguay, Uruguay and Venezuela, for peanuts and peanut products, many countries in this region have no regulations in place. In relation to the impacts on human health as a result of dietary exposure of aflatoxins, there is a lack of reported studies, either biomarker investigations or evaluating the incidences of HCC and the link to aflatoxins in food (Scussel 2004). In 2013, Wu et al. published research investigating the adequacy of global regulatory standards to protect human health. The focus was on HCC as other health impact evidence was weak. Analysis of maize and peanut consumption per adult/country and HBV prevalence/country were included (if available). Two scenarios were explored and compared to the legislative MLs for each country, contamination levels resulting in a lifetime HCC increased risk of less than 1 in 100,000 and 1 in 10,000 in the population. The results indicated if adequate control was considered to be, that dietary aflatoxin exposure would not cause an increase of 1/100,000 HCC cases over a lifetime, then the majority of regulatory standards are not protective. The exception was the EU, who could actually relax their standards due to low HBV incidents and low dietary exposure. Yet as we know, the EU has some of the strictest regulations for aflatoxins in peanuts and peanut products. In contrast, if it was considered adequate that exposure would not cause an increase of 1/10,000 HCC cases over a lifetime, then most countries have protective MLs (Wu et al. 2013).
Impact of Regulatory Limits on Trade
In terms of the impact of aflatoxin regulations on trade, the literature is not only limited but relies mainly on descriptive rather than quantitative studies (Agyekum and Jolly 2017). Most of the focus of these has been on evaluating the effects of the EU regulations, as these are the strictest when compared with the international Codex Alimentarius and other legislative standards adopted by countries. Not surprisingly, several of the studies have investigated the impact on exporting countries in the developing world. In 2001, Otsuki et al. evaluated the impact of regulations on trade, specifically on African exports of peanut and peanut products, important commodities for African countries (Otsuki et al. 2001). African exporters were concerned that agricultural practices and available technologies would hinder compliance with strict EU harmonised standards that were to be enforced by 2002. Using gravity models, the researchers estimated that revenue losses for African exporters as a result of the EU setting much stricter regulations than those enforced internationally by Codex Alimentarius would be in the region of 720,000 million US Dollars (Otsuki et al. 2001). Contrary to this, Giorgi and Tandon (2010), reported that from 1998 to 2001, exports from the same African countries increased from 718 to 921 million Euros. Moreover, following the introduction of the tighter regulations on peanuts and peanut products in the EU in 2002, exports from these countries increased 1–2% every year to 2005. In another study, focusing on the effects of pricing and quantity (equilibrium displacement modelling, EDM), Agyekum and Jolly (2017) found that enforcement of tighter regulations for aflatoxin imports in the EU may benefit some exporters. They compared the impact on peanut exporters in China, the USA and developing countries and reported that while the USA and developing countries experienced decreases in export prices and quantities, China actually benefited. Moreover, the USA experienced more significant economic losses than those seen in developing countries, although as a more affluent country, the USA can more easily tolerate such fluctuations in the market (Agyekum and Jolly 2017). Additional contrary findings on the impact of the EU regulatory MLs on peanut product exports from Africa have been observed (Wu 2004). The author reported that losses would be in the region of 40 million US Dollars, much less than reported in other studies. This was supported in another study using gravity models (Xiong and Beghin 2012). The results highlighted that there were no significant effects in exports in terms of volumes or in their ability to trade. They reasoned that agricultural and storage practices and trade costs limited export potential rather than EU import policies. In the US, it was estimated that losses to the Southeast peanut industry amounted to 25 million dollars per year (1993–1996 crop years). These losses included the drop in value of the commodity and those incurred from handling the contaminated peanuts but not production costs associated with the crop (Robens and Cardwell 2003).
Management of Aflatoxin Contamination
As intimated, it is impossible to remove all traces of aflatoxins in food commodities as they are naturally occurring toxins, however pre- and post-harvest intervention strategies do exist that will help reduce contamination to lower levels. These include GAP, GMP and Hazard Analysis Critical Control Point (HACCP), based on hazard identification, introducing controls and monitoring these controls throughout manufacturing (Matumba et al. 2017). Major peanut producers follow The Code of Practice for the Prevention and Reduction of Aflatoxin Contamination in Peanuts (CAC 2004). This provides guidance to those trading peanuts internationally for human consumption. Moreover, post-harvest decontamination strategies may be employed to reduce the risks to humans and animals. These include physical methods such as sorting, washing, milling and thermal treatment, chemical decontamination with acids, alkalis and oxidising agents and biological detoxification using microorganisms and enzymes (Marshall et al. 2020). Furthermore, simple cooking methods have been shown to reduce the levels of aflatoxins in peanuts. In a study performed in India, the researchers investigated various common cooking methods (frying, pressure-cooking and roasting) to evaluate their effectiveness at reducing AFB1 in peanuts. The findings indicated that roasting was the most effective method to reduce aflatoxin B1 content in peanuts, closely followed by pressure cooking and finally frying (Dhanshetty et al. 2021). However, these mitigation strategies rely on the farmers, traders and processors within the food supply chain of being aware of the hazards and risks posed by aflatoxin contamination and having knowledge of prevention/mitigation strategies (Matumba et al. 2017).
In developed countries the risks associated with contaminated aflatoxin products and the management of these contaminants is very well understood, however the scientific literature has highlighted that in developing countries this is not always the case. In Sub-Saharan Africa, knowledge of the human risks from exposure to aflatoxins is poor and often even primary health care workers do not relate HCC or other health effects to dietary exposure to aflatoxins (Stepman 2018). Even if farmers have knowledge of the problems with aflatoxins, often they do not have the resources to improve the situation (Stepman 2018). In Ethiopia, it was revealed that public awareness of the risks of consuming mouldy foods was extremely limited and that farmers and traders had little knowledge of the public health implications of exposure to aflatoxins. In addition, malpractice by traders, adding water to peanuts, to increase the weight and therefore gain a higher commodity price creates more favourable conditions for the growth of fungi and therefore possible aflatoxin contamination (Mamo et al. 2020). Research investigating the perception, knowledge and management of aflatoxins by peanut farmers in India highlighted that they were unaware of the health risks associated with consumption of aflatoxin contaminated peanuts or peanut products unlike traders who did understand the problems. Generally, the farmers did not control aflatoxin contamination, unless accidently by GAP, as no incentives were in place in the domestic market to do this. They were only interested in increasing yields rather than improving quality (Kumar and Popat 2010). Studies by Kumar and Popat (2010) and Azaman et al. (2016) also highlighted that socioeconomic characteristics influenced their knowledge on aflatoxins. The consensus from these studies is that producers and consumers should be educated regarding the health and economic risks of aflatoxin-contaminated products. Furthermore, farmers must be trained to recognise aflatoxin contamination and in both pre- and post-harvest strategies to reduce contamination including GAP, storage conditions and easily adopted decontamination methods and that partnerships should be formed between all stakeholders to develop prevention and mitigation policies to better control aflatoxin contamination (Mamo et al. 2020; Stepman 2018; Kumar and Popat 2010; Azaman et al. 2016; Meijer et al. 2021).
Conclusions
This systematic literature review has examined scientific and grey literature to explore the challenges and impacts associated with global legislation for aflatoxins in peanuts and peanut commodities.
Several observations have been noted in relation to aflatoxin national standards for peanuts and peanut products. Firstly, they have been shown to be inconsistent with no global harmonisation. Many countries have harmonised MLs to ensure free trade amongst them such as, the EU, Australia and New Zealand, Latin America (MERCOSUR) and of course Codex Alimentarius that covers international trade. However, while in terms of trade, global harmonisation of MLs for peanuts and peanut products would be extremely beneficial, it is unlikely that from a human health perspective, the same could be said. This is because exposure to aflatoxins from peanuts and peanut products is highly variable around the world depending on dietary preferences and levels of crop contamination. While it is positive that many countries have adopted legislation, and some trading partners share similar MLs, more rigorous limits have been set in the developed world, particularly in the EU to protect public health. Conversely, even though aflatoxin contamination of peanuts and peanut products is a major food safety issue in many developing countries, often the MLs established are much more relaxed. Since food insecurity is a huge issue in these regions, no matter what regulations are in place, or what the contamination levels are in these products, the populations have no choice but to consume them. This emphasises the compromise between food security and food safety. Although risk assessments performed by countries generally follow the same approach, different criteria, such as dietary source, the population assessed and the inclusion/exclusion of non-compliant products used result in disparate MLs designed to protect consumers from the harmful effects of aflatoxins in peanuts and peanut products and it is very difficult to harmonise these, since dietary exposure throughout the world varies greatly. It has also been highlighted that for many countries, generally those in the low-income and lower middle-income countries that are more affected by aflatoxin contamination in peanuts, no legislative limits exist, therefore the economic and health burdens on these populations is notably worsened. Additionally, it has been recognised that even if legislation existed in such countries, because of food insecurity, would this actually improve health protection? The current and worsening food crisis caused by the Ukraine/Russia conflict will only serve to exacerbate this.
A range of knowledge gaps have been identified, covering areas of fundamental and applied research to a lack of educational strategies to equip citizens, particularly in developing countries, with the means to reduce contamination and protect health. Researchers have highlighted the lack of knowledge of the impact of climate change on aflatoxin contamination, urging further development of predictive modelling to include different geographical regions and crops and crucially, its application in countries where the risk is greatest. Fundamental research relating to the role of aflatoxins in child stunting, immunomodulation, Reye’s syndrome and Kwashiorkor is necessary, including evaluation of the social and economic impacts. Furthermore, the lack of occurrence and exposure data relating to peanuts and peanut products in many developing countries makes the risk assessment and hence the establishment of meaningful maximum limits difficult. In many countries, in Africa, Asia and South America this information is extremely limited and it is in these regions where consumption of peanuts and peanut products is greatest. Occurrence data may be difficult to obtain due to lack of knowledge of good sampling regimes and the analytical capabilities required to monitor food products for aflatoxins. Dietary exposure assessments should be made, if possible by monitoring exposure biomarkers to get an accurate appraisal on the situation rather than using dietary recall questionnaires.
With regard to trade, much of the information retrieved was descriptive with few quantitative studies dealing with the economic impacts of aflatoxin legislation. This emphasises the need for more quantitative studies to provide the evidence base when implementing aflatoxin policy for these commodities.
Moreover, what happens to exports that do not meet the regulatory requirements of the importing country? There is some evidence to suggest that if tested in the exporting country they enter the domestic market. To what extent does this happen? If tested in the importing country, are they destroyed or shipped to countries with different standards or is the testing limited?
Finally, in terms of education, the evidence suggests a lack of knowledge of the extent of the problems, associated health risks and mitigation strategies in relation to aflatoxin contamination in peanuts and peanut products in developing countries. More emphasis should be placed on the need to educate all stakeholders on the problem of aflatoxins and how they are formed, the public health risk associated with consumption of aflatoxin-contaminated peanuts and peanut products and how to mitigate against these toxins. The key imperative is to ensure that those most at risk do not have to choose between eating contaminated food or going without.
The findings of this systematic review have provided a comprehensive overview and understanding of the decisions required to deliver safe food and protect public health, expose knowledge or evidence gaps and therefore promote further research to address these shortcomings, in the context of aflatoxins in peanuts and peanut products.
Data Availability
The datasets used and/or analysed during the current study are available from the corresponding author on reasonable request.
References
Abbott P, Baines J, Fox P, Graf L, Kelly L, Stanley G, Tomaska L (2003) Review of the regulations for contaminants and natural toxicants. Food Control 14(6):383–389. https://doi.org/10.1016/S0956-7135(03)00040-9
Agyekum M, Jolly CM (2017) Peanut trade and aflatoxin standards in Europe: economic effects on trading countries. J Policy Model 39(1):114–128. https://doi.org/10.1016/j.jpolmod.2016.08.004
Anukul N, Vangnai K, Mahakarnchandkul W (2013) Significance of regulation limits in mycotoxin contamination in Asia and risk management programs at the national level. J Food Drug Anal 21(3):227–241. https://doi.org/10.1016/j.jfda.2013.07.009
Azaman NNM, Kamarulzaman NH, Shamsudin MN, Selamat J (2016) Stakeholders’ knowledge, attitude, and practices (KAP) towards aflatoxins contamination in peanut-based products. Food Control 70:249–256. https://doi.org/10.1016/j.foodcont.2016.05.058
Barlow S, Renwick AG, Kleiner J, Bridges JW, Busk L, Dybing E, Edler L, Eisenbrand G, Fink-Gremmels J, Knaap A, Kroes R, Liem D, Müller DJG, Page S, Rolland V, Schlatter J, Tritscher A, Tueting W, Würtzen G (2006) Risk assessment of substances that are both genotoxic and carcinogenic. Report of an International Conference organized by EFSA and WHO with support of ILSI Europe. Food Chem Toxicol 44(10):1636–1650. https://doi.org/10.1016/j.fct.2006.06.020
Basicplanet (2021) List of Top Largest Peanuts Producing Countries in the World. https://www.basicplanet.com/list-top-largest-peanuts-producing-countries-world/. Accessed 21 July 2021.
Bennett JW, Klich M (2003) Mycotoxins. Clin Microbiol Rev 16(3):497. https://doi.org/10.1128/cmr.16.3.497-516.2003
Berg T (2003) How to establish international limits for mycotoxins in food and feed? Food Control 14(4):219–224. https://doi.org/10.1016/S0956-7135(02)00021-X
CAC (1995) Codex Alimentarius international food standards, General standard for contaminants and toxins in food and feed. CXS 193–1995. Adopted in 1995. Revised in 1997, 2006, 2008, 2009. Amended in 2010, 2012, 2013, 2014, 2015, 2016, 2017. Food and Agriculture Organization of the United Nations (FAO), the World Health Organization (WHO). http://www.fao.org/fao-who-codexalimentarius/sh-proxy/en/?lnk=1&url=https%253A%252F%252Fworkspace.fao.org%252Fsites%252Fcodex%252FStandards%252FCXS%2B193-1995%252FCXS_193e.pdf. Accessed 19 July 2021
CAC (2004) Food and Agriculture Organization of the United Nations/World Health Organization. Code of Practice for the Prevention and Reduction of Aflatoxin Contamination in Peanuts, CAC/RCP 55 – 2004. http://www.refixcommodities.com/wp-content/uploads/2019/10/Code-of-Practices.pdf. Accessed 16 Dec 2021
CAC (2013) Procedural Manual. Codex Alimentarius Commission. World Health Organisation/Food and Agriculture Organisation of the United Nations, Rome, Italy. http://www.fao.org/3/i3243e/i3243e.pdf Accessed 19 July 2021.
CASP (2018) CASP Checklists. https://casp-uk.net/casp-tools-checklists/. Accessed 8 June 2021.
CAST (2003) Mycotoxins: risks in plant, animal and human systems. Task Force Report, No. 139. The Council for Agricultural Science and Technology Agricultural Science. Iowa, USA. https://www.cast-science.org/publication/mycotoxins-risks-in-plant-animal-and-human-systems/. Accessed 19 July 2021.
CFIA (2017) Canadian Food Inspection Agency (CFIA) RG-8 Regulatory guidance. Contaminants in feed (formerly RG-1, Chapter 7), Section 1: mycotoxins in livestock feed. http://www.inspection.gc.ca/animals/feeds/regulatory-guidance/rg-8/eng/1347383943203/1347384015909. Accessed 19 July 2021.
Chang AS, Sreedharan A, Schneider KR (2013) Peanut and peanut products: a food safety perspective. Food Control 32(1):296–303. https://doi.org/10.1016/j.foodcont.2012.12.007
Chu YJ, Yang HI, Wu HC, Lee MH, Liu J, Wang LY, Lu SN, Jen CL, You SL, Santella RM, Chen CJ (2018) Aflatoxin B1 exposure increases the risk of hepatocellular carcinoma associated with hepatitis C virus infection or alcohol consumption. Eur J Cancer 94:37–46. https://doi.org/10.1016/j.ejca.2018.02.010
Cressey PJ (2009) Mycotoxin risk management in New Zealand and Australian food. World Mycotoxin J 2(2):113–118. https://doi.org/10.3920/WMJ2008.1123
Dhanshetty M, Elliott CT, Banerjee K (2021) Decontamination of aflatoxin B1 in peanuts using various cooking methods. J Food Sci Technol 58(7):2547–2554. https://doi.org/10.1007/s13197-020-04761-3
Diaz DE (2005) The mycotoxin blue book. Nottingham University Press, Nottingham
EC (1993) European Council Regulation (EEC) No 315/93 of 8 February 1993 laying down Community procedures for contaminants in food. https://eur-lex.europa.eu/legal-content/EN/TXT/PDF/?uri=CELEX:01993R0315-20090807&qid=1627992074036&from=en. Accessed 19 July 2021
EC (1994) Mycotoxins in human nutrition and health. Agro-Industrial Research Division. Directorate-General XII for Scientific Research and Development
EC (1998) Commission Regulation (EC) No 1525/98 of 16 July 1998 amending Regulation (EC) No 194/97 of 31 January 1997 setting maximum levels for certain contaminants in foodstuffs. https://op.europa.eu/en/publication-detail/-/publication/b9fdaf6a-63f5-43fe-91a5-6bd2abc92de4/language-en. Accesed 19 July 2021
EC (2001) Commission Regulation (EC) No 466/2001 of 8 March 2001 setting maximum levels for certain contaminants in foodstuffs. https://op.europa.eu/en/publication-detail/-/publication/52b2484d-39e0-4aa9-ba19-4b13a887bb1c. Accessed 19 July 2021
EC (2002) Regulation (EC) No 178/2002 of The European Parliament and of The Council of 28 January 2002 laying down the general principles and requirements of food law, establishing the European Food Safety Authority and laying down procedures in matters of food safety. https://eur-lex.europa.eu/legal-content/EN/TXT/PDF/?uri=CELEX:02002R0178-20140630&rid=1. Accessed 29 July 2021
EC (2006) Commission Regulation (EC) No 1881/2006 of 19 December 2006 setting maximum levels for certain contaminants in foodstuffs. https://eur-lex.europa.eu/LexUriServ/LexUriServ.do?uri=OJ:L:2006:364:0005:0024:EN:PDF. Accessed 19 July 2021
EFSA (2005) Opinion of the Scientific Committee on a request from EFSA related to a harmonised approach for risk assessment of substances which are both genotoxic and carcinogenic. European Food Safety Authority. EFSA J 282:1–31
Eskola M, Altieri A, Galobart J (2018) Overview of the activities of the European Food Safety Authority on mycotoxins in food and feed. World Mycotoxin J 11(2):277–289. https://doi.org/10.3920/WMJ2017.2270
Eskola M, Kos G, Elliott CT, Hajšlová J, Mayar S, Krska R (2020) Worldwide contamination of food-crops with mycotoxins: validity of the widely cited “FAO estimate” of 25. Crit Rev Food Sci Nutr 60(16):2773–2789. https://doi.org/10.1080/10408398.2019.1658570
EU (2010) Commission Regulation (EU) No 178/2010 of 2 March 2010 amending Regulation (EC) No 401/2006 as regards groundnuts (peanuts), other oilseeds, tree nuts, apricot kernels, liquorice and vegetable oil. Official Journal of the European Union L 52/32
EU (2021) Rapid Alert System for Food and Feed (RASFF). https://ec.europa.eu/food/food/rasff-food-and-feed-safety-alerts_en. Accessed 28 June 2021
FAMIC (2011) Aflatoxin. Food and Agricultural Materials Inspection Centre (FAMIC). http://www.famic.go.jp/ffis/oie/obj/hc_aflatoxin.pdf. Accessed 19 July 2021
FAO/WHO (2004) Worldwide regulations for mycotoxins in food and feed, FAO Food and Nutrition Paper 81. Food and Agriculture Organisation of the United Nations, Rome, Italy. http://www.fao.org/3/y5499e/y5499e.pdf. Accessed 19 July 2021
FAO/WHO (2005) Joint FAO/WHO Expert Committee on Food Additives, Sixty-fourth meeting, Rome, 8–17 February 2005. http://www.fao.org/3/at877e/at877e.pdf. Accessed 29 July 2021
FAO/WHO (2017) Food and Agriculture Organization of the United Nations/World Health Organization. Aflatoxins. Evaluation of certain contaminants in food (Eighty-third report of the Joint FAO/WHO Expert Committee on Food Additives (JECFA). pp 11–40
FAO/WHO (2021) Food and Agriculture Organisation of the United Nations/World Health Organisation Codex Alimentarius. http://www.fao.org/fao-who-codexalimentarius/about-codex/en/#c453333. Accessed 21 July 2021
FAOSTAT (2019) Food and Agriculture Organisation of the United Nations, FAOSTAT. http://www.fao.org/statistics/en/. Accessed 21 July 2021
FDA (1980) Food and Drug Administration of the United States Compliance Policy Guide Sec. 570.375 Aflatoxins in Peanuts and Peanut Products: Guidance for FDA Staff. https://www.fda.gov/media/72073/download. Accessed 19 July 2021
FDA (2021) US Food and Drug Administration Investigations Operations Manual (IOM). https://www.fda.gov/inspections-compliance-enforcement-and-criminal-investigations/inspection-references/investigations-operations-manual. Accessed 30 July 2021
FOODAKAI (2021) EU RASFF Alerts for aflatoxins from 01 January 2016 until 31 December 2020. https://app.foodakai.com/users/sign_in. Accessed 17 June 2021
FSANZ (2017) Australia New Zealand Food Standards Code, 2017, Schedule 19, Maximum levels of contaminants and natural toxicants. Prepared by Food Standards Australia New Zealand (FSANZ) on 13 April 2017. Australian Government, Federal Register of Legislation. https://www.legislation.gov.au/Details/F2017C00333. Accessed 19 July 2021
FSSAI (2011) Food Safety and Standards Authority of India (FSSAI) Food Safety and Standards (Contaminants, Toxins and Residues) Regulations, 2011, F. No. 2-15015/30/2010. https://www.fssai.gov.in/upload/uploadfiles/files/Compendium_Contaminants_Regulations_20_08_2020.pdf. Accessed 19 July 2021
Giorgi L (2013) The pitfalls of European risk governance: a question of design or application? Some empirical results from the food safety sector. Innovation 26(4):365–375. https://doi.org/10.1080/13511610.2013.776948
Giorgi L, Tandon A (2010) Putting risk management to the test or why it is ineffectual to separate risk assessment from risk management: the story of maximum levels for aflatoxins. Eur J Risk Regul 1(2):123–135. https://doi.org/10.1017/S1867299X00000210
Gong Y, Hounsa A, Egal S, Turner PC, Sutcliffe AE, Hall AJ, Cardwell K, Wild CP (2004) Postweaning exposure to aflatoxin results in impaired child growth: a longitudinal study in Benin. West Afr Environ Health Perspect 112(13):1334–1338. https://doi.org/10.1289/ehp.6954
Haerani H, Apan A, Basnet B (2020) The climate-induced alteration of future geographic distribution of aflatoxin in peanut crops and its adaptation options. Mitig Adapt Strat Glob Change 25(6):1149–1175. https://doi.org/10.1007/s11027-020-09927-0
Henry SH, Scheuplein RJ, Bowers J, Tollefson L (1993) U.S. Food and Drug Administration approach to risk assessment of aflatoxin in human foods. Qual Assur 2(1–2):71–77
Huggett A, Petersen BJ, Walker R, Fisher CE, Notermans SHW, Rombouts FM, Abbott P, Debackere M, Hathaway SC, Hecker EFF, Knaap AGA, Kuznesof PM, Meyland I, Moy G, Narbonne JF, Paakkanen J, Smith MR, Tennant D, Wagstaffe P, Wargo J, Würtzen G (1998) Towards internationally acceptable standards for food additives and contaminants based on the use of risk analysis. Environ Toxicol Pharmacol 5(4):227–236. https://doi.org/10.1016/S1382-6689(98)00017-9
IARC (2002) IARC monographs on the evaluation of carcinogenic risks to humans some traditional herbal medicines, some mycotoxins, naphthalene and styrene. IARC Press, Lyon, France Volume 82. https://monographs.iarc.who.int/wp-content/uploads/2018/06/mono82.pdf. Accessed 19 July 2021
IARC (2012a) Improving public health through mycotoxin control. IARC Scientific Publication No. 158. Lyon, France: International Agency for Research on Cancer. https://publications.iarc.fr/Book-And-Report-Series/Iarc-Scientific-Publications/Improving-Public-Health-Through-Mycotoxin-Control-2012a. Accessed 19 July 2021
IARC (2012b) Monographs on the evaluation of carcinogenic risks to humans: chemical agents and related occupations. A review of human carcinogens. Lyon, France: International Agency for Research on Cancer 100F:224–248. https://publications.iarc.fr/Book-And-Report-Series/Iarc-Monographs-On-The-Identification-Of-Carcinogenic-Hazards-To-Humans/Chemical-Agents-And-Related-Occupations-2012b. Accessed 19 July 2021
IARC (2015) Mycotoxin control in low- and middle-income countries. IARC Working Group Report Volume 9. Lyon, France: International Agency for Research on Cancer. https://publications.iarc.fr/Book-And-Report-Series/Iarc-Working-Group-Reports/Mycotoxin-Control-In-Low--And-Middle-income-Countries-2015. Accessed 17 December 2021
Jallow A, Xie HL, Tang XQ, Qi Z, Li PW (2021) Worldwide aflatoxin contamination of agricultural products and foods: from occurrence to control. Compr Rev Food Sci Food Saf 20(3):2332–2381. https://doi.org/10.1111/1541-4337.12734
Khlangwiset P, Shephard GS, Wu F (2011) Aflatoxins and growth impairment: a review. Crit Rev Toxicol 41(9):740–755. https://doi.org/10.3109/10408444.2011.575766
Knutsen HK, Alexander J, Barregard L, Bignami M, Bruschweiler B, Ceccatelli S, Cottrill B, Dinovi M, Edler L, Grasl-Kraupp B, Hogstrand C, Hoogenboom L, Nebbia CS, Oswald IP, Rose M, Roudot AC, Schwerdtle T, Vleminckx C, Vollmer G, Wallace H, Furst P, Baert K, Cortinas Abrahantes J, Dujardin B, Ferrini K, Petersen A, Cha EPCF (2018) Effect on public health of a possible increase of the maximum level for “aflatoxin total” from 4 to 10 μg/kg in peanuts and processed products thereof, intended for direct human consumption or use as an ingredient in foodstuffs. EFSA J. https://doi.org/10.2903/j.efsa.2018.5175
Kugley S, Wade A, Thomas J, Mahood Q, Jørgensen AMK, Hammerstrøm K, Sathe N (2017) Searching for studies: a guide to information retrieval for Campbell systematic reviews. Campbell Syst Rev 13(1):1–73. https://doi.org/10.4073/cmg.2016.1
Kumar GDS, Popat MN (2010) Farmers’ perceptions, knowledge and management of aflatoxins in groundnuts (Arachis hypogaea L.) in India. Crop Protect 29(12):1534–1541. https://doi.org/10.1016/j.cropro.2010.08.019
Ladeira C, Frazzoli C, Orisakwe OE (2017) Engaging one health for non-communicable diseases in Africa: perspective for mycotoxins. Front Public Health. https://doi.org/10.3389/fpubh.2017.00266
Magan N, Medina A, Aldred D (2011) Possible climate-change effects on mycotoxin contamination of food crops pre- and postharvest. Plant Pathol 60(1):150–163. https://doi.org/10.1111/j.1365-3059.2010.02412.x
Mamo FT, Abate BA, Tesfaye K, Nie C, Wang G, Liu Y (2020) Mycotoxins in Ethiopia: a review on prevalence, economic and health impacts. Toxins (basel). https://doi.org/10.3390/toxins12100648
Marroquín-Cardona AG, Johnson NM, Phillips TD, Hayes AW (2014) Mycotoxins in a changing global environment—a review. Food Chem Toxicol 69:220–230. https://doi.org/10.1016/j.fct.2014.04.025
Marshall H, Meneely JP, Quinn B, Zhao YJ, Bourke P, Gilmore BF, Zhang GT, Elliott CT (2020) Novel decontamination approaches and their potential application for post-harvest aflatoxin control. Trends Food Sci Technol 106:489–496. https://doi.org/10.1016/j.tifs.2020.11.001
Matacic C (2016) Fungal toxins are poisoning Africa's children, says new report. "Invisible" epidemic could lead to stunting and delayed development. https://www.science.org/content/article/fungal-toxins-are-poisoning-africa-s-children-says-new-report. Accessed 16 Dec 2021
Matumba L, Van Poucke C, Njumbe Ediage E, De Saeger S (2017) Keeping mycotoxins away from the food: does the existence of regulations have any impact in Africa? Crit Rev Food Sci Nutr 57(8):1584–1592. https://doi.org/10.1080/10408398.2014.993021
Medina Á, González-Jartín JM, Sainz MJ (2017) Impact of global warming on mycotoxins. Curr Opin Food Sci 18:76–81. https://doi.org/10.1016/j.cofs.2017.11.009
Meijer N, Kleter G, de Nijs M, Rau ML, Derkx R, van der Fels-Klerx HJ (2021) The aflatoxin situation in Africa: systematic literature review. Compr Rev Food Sci Food Saf 20(3):2286–2304. https://doi.org/10.1111/1541-4337.12731
MordorIntelligence (2021) Peanut meal market—growth, trends, Covid-19 impact, and forecasts (2022–2027). https://www.mordorintelligence.com/industry-reports/peanut-meal-market#. Accessed 15 Dec 2021
Moretti A, Logrieco AF, Susca A (2017) Mycotoxins: an underhand food problem. Methods Mol Biol 1542:3–12. https://doi.org/10.1007/978-1-4939-6707-0_1
Mupunga I, Mngqawa P, Katerere D (2017) Peanuts, aflatoxins and undernutrition in children in Sub-Saharan Africa. Nutrients 9(12):1287. https://doi.org/10.3390/nu9121287
Norlia M, Jinap S, Nor-Khaizura MAR, Radu S, Samsudin NIP, Azri FA (2019) Aspergillus section flavi and aflatoxins: occurrence, detection, and identification in raw peanuts and peanut-based products along the supply chain. Front Microbiol 10:2602. https://doi.org/10.3389/fmicb.2019.02602
O’Brien J, Renwick AG, Constable A, Dybing E, Müller DJG, Schlatter J, Slob W, Tueting W, van Benthem J, Williams GM, Wolfreys A (2006) Approaches to the risk assessment of genotoxic carcinogens in food: a critical appraisal. Food Chem Toxicol 44(10):1613–1635. https://doi.org/10.1016/j.fct.2006.07.004
Otsuki T, Wilson JS, Sewadeh M (2001) What price precaution? European harmonisation of aflatoxin regulations and African groundnut exports. Eur Rev Agric Econ 28(3):263–283. https://doi.org/10.1093/erae/28.3.263
Park DL, Stoloff L (1989) Aflatoxin control—how a regulatory agency managed risk from an unavoidable natural toxicant in food and feed. Regul Toxicol Pharmacol 9(2):109–130. https://doi.org/10.1016/0273-2300(89)90029-9
Richard JL (2008) Discovery of aflatoxins and significant historical features. Toxin Rev 27(3–4):171–201. https://doi.org/10.1080/15569540802462040
Robens J, Cardwell K (2003) The costs of mycotoxin management to the USA: management of aflatoxins in the United States. J Toxicol Toxin Rev 22(2–3):139–152. https://doi.org/10.1081/TXR-120024089
Scussel VM (2004) Aflatoxin and food safety: recent south American perspectives. J Toxicol-Toxin Rev 23(2–3):179–216. https://doi.org/10.1081/txr-200027813
Shephard GS (2003) Aflatoxin and food safety: recent African perspectives. J Toxicol-Toxin Rev 22(2–3):267–286. https://doi.org/10.1081/txr-120024094
Shephard GS (2008) Risk assessment of aflatoxins in food in Africa. Food Addit Contam Part A 25(10):1246–1256. https://doi.org/10.1080/02652030802036222
Sirma AJ, Lindahl JF, Makita K, Senerwa D, Mtimet N, Kang’ethe EK, Grace D (2018) The impacts of aflatoxin standards on health and nutrition in sub-Saharan Africa: the case of Kenya. Glob Food Secur 18:57–61. https://doi.org/10.1016/j.gfs.2018.08.001
Songsermsakul P (2015) Mycotoxins contamination of food in Thailand (2000–2010): food safety concerns for the world food exporter. Int Food Res J 22(2):426–434
Stepman F (2018) Scaling-up the impact of aflatoxin research in Africa. The role of social sciences. Toxins (basel). https://doi.org/10.3390/toxins10040136
Sugita-Konishi Y, Sato T, Saito S, Nakajima M, Tabata S, Tanaka T, Norizuki H, Itoh Y, Kai S, Sugiyama K, Kamata Y, Yoshiike N, Kumagai S (2010) Exposure to aflatoxins in Japan: risk assessment for aflatoxin B1. Food Addit Contam Part A 27(3):365–372. https://doi.org/10.1080/19440040903317497
Tricco AC, Lillie E, Zarin W, O’Brien KK, Colquhoun H, Levac D, Moher D, Peters MDJ, Horsley T, Weeks L, Hempel S, Akl EA, Chang C, McGowan J, Stewart L, Hartling L, Aldcroft A, Wilson MG, Garritty C, Lewin S, Godfrey CM, MacDonald MT, Langlois EV, Soares-Weiser K, Moriarty J, Clifford T, Tunçalp Ö, Straus SE (2018) PRISMA extension for scoping reviews (PRISMA-ScR): checklist and explanation. Ann Intern Med 169(7):467–473. https://doi.org/10.7326/M18-0850
Udomkun P, Wiredu AN, Nagle M, Bandyopadhyay R, Müller J, Vanlauwe B (2017) Mycotoxins in Sub-Saharan Africa: present situation, socio-economic impact, awareness, and outlook. Food Control 72:110–122. https://doi.org/10.1016/j.foodcont.2016.07.039
UN (2019) UN News global perspective human stories: can we feed the world and ensure no one goes hungry? https://news.un.org/en/story/2019/10/1048452. Accessed 16 Dec 2021.
USDA (2018) United States Department of Agriculture. China Releases Standard for Maximum Levels of Mycotoxins in Foods. USDA Foreign Agriculture Service, Global Agriculture Information Network (GAIN) Report CH18026. https://apps.fas.usda.gov/newgainapi/api/report/downloadreportbyfilename?filename=China%20Releases%20Standard%20for%20Maximum%20Levels%20of%20Mycotoxins%20in%20Foods%20_Beijing_China%20-%20Peoples%20Republic%20of_5-9-2018.pdf. Accessed 19 July 2021
Van Der Fels-Klerx HJ, Liu C, Battilani P (2016) Modelling climate change impacts on mycotoxin contamination. World Mycotoxin J 9(5):717–726. https://doi.org/10.3920/WMJ2016.2066
Van Egmond HP, Jonker MA (2004) Worldwide regulations on aflatoxins—the situation in 2002. J Toxicol Toxin Rev 23(2–3):273–293. https://doi.org/10.1081/TXR-200027844
Van Egmond HP, Schothorst RC, Jonker MA (2007) Regulations relating to mycotoxins in food: PPPPerspectives in a global and European context. Anal Bioanal Chem 389(1):147–157. https://doi.org/10.1007/s00216-007-1317-9
Wambui JM, Karuri EG, Ojiambo JA, Njage PMK (2016) Adaptation and mitigation options to manage aflatoxin contamination in food with a climate change perspective. World Mycotoxin J 9(5):875–888. https://doi.org/10.3920/WMJ2016.2109
Warnatzsch EA, Reay DS, Camardo Leggieri M, Battilani P (2020) Climate change impact on aflatoxin contamination risk in Malawi’s maize crops. Front Sustain Food Syst. https://doi.org/10.3389/fsufs.2020.591792
WHO (2021) World Health Organisation Global Environment Monitoring System (GEMS)/Food Contamination Monitoring and Assessment Programme. https://www.who.int/teams/nutrition-and-food-safety/databases/global-environment-monitoring-system-food-contamination. Accessed 30 July 2021
Wilson DM, Mubatanhema W, Jurjevic Z (2002) Biology and ecology of mycotoxigenic Aspergillus species as related to economic and health concerns. Adv Exp Med Biol 504:3–17. https://doi.org/10.1007/978-1-4615-0629-4_2
WTO (1995) World Trade Organisation agreement on the application of sanitary and phytosanitary measures. https://www.wto.org/English/Docs_E/legal_e/15-sps.pdf. Accessed 21 July 2021
Wu F (2004) Mycotoxin risk assessment for the purpose of setting international regulatory standards. Environ Sci Technol 38(15):4049–4055. https://doi.org/10.1021/es035353n
Wu F, Mitchell NJ (2016) How climate change and regulations can affect the economics of mycotoxins. World Mycotoxin J 9(5):653–663. https://doi.org/10.3920/WMJ2015.2015
Wu F, Munkvold GP (2008) Mycotoxins in ethanol co-products: modeling economic impacts on the livestock industry and management strategies. J Agric Food Chem 56(11):3900–3911. https://doi.org/10.1021/jf072697e
Wu F, Bhatnagar D, Bui-Klimke T, Carbone I, Hellmich R, Munkvold G, Paul P, Payne G, Takle E (2010) Climate change impacts on mycotoxin risks in US maize. World Mycotoxin J 4(1):79–93. https://doi.org/10.3920/WMJ2010.1246
Wu F, Stacy SL, Kensler TW (2013) Global risk assessment of aflatoxins in maize and peanuts: are regulatory standards adequately protective? Toxicol Sci 135(1):251–259. https://doi.org/10.1093/toxsci/kft132
Xiong B, Beghin J (2012) Does European aflatoxin regulation hurt groundnut exporters from Africa? Eur Rev Agric Econ 39(4):589–609. https://doi.org/10.1093/erae/jbr062
Funding
The authors declare that no funds, grants, or other support were received during the preparation of this manuscript.
Author information
Authors and Affiliations
Contributions
All authors contributed to the study conception and design. Data retrieval and synthesis were performed by JPM, OK and SAH. The first draft of the manuscript was written by JPM and all authors commented on previous versions of the manuscript. All authors read and approved the final manuscript.
Corresponding author
Ethics declarations
Conflict of interest
The authors have no relevant financial or non-financial interests to disclose.
Additional information
Publisher's Note
Springer Nature remains neutral with regard to jurisdictional claims in published maps and institutional affiliations.
Supplementary Information
Below is the link to the electronic supplementary material.
Rights and permissions
Open Access This article is licensed under a Creative Commons Attribution 4.0 International License, which permits use, sharing, adaptation, distribution and reproduction in any medium or format, as long as you give appropriate credit to the original author(s) and the source, provide a link to the Creative Commons licence, and indicate if changes were made. The images or other third party material in this article are included in the article's Creative Commons licence, unless indicated otherwise in a credit line to the material. If material is not included in the article's Creative Commons licence and your intended use is not permitted by statutory regulation or exceeds the permitted use, you will need to obtain permission directly from the copyright holder. To view a copy of this licence, visit http://creativecommons.org/licenses/by/4.0/.
About this article
Cite this article
Meneely, J.P., Kolawole, O., Haughey, S.A. et al. The Challenge of Global Aflatoxins Legislation with a Focus on Peanuts and Peanut Products: A Systematic Review. Expo Health 15, 467–487 (2023). https://doi.org/10.1007/s12403-022-00499-9
Received:
Revised:
Accepted:
Published:
Issue Date:
DOI: https://doi.org/10.1007/s12403-022-00499-9